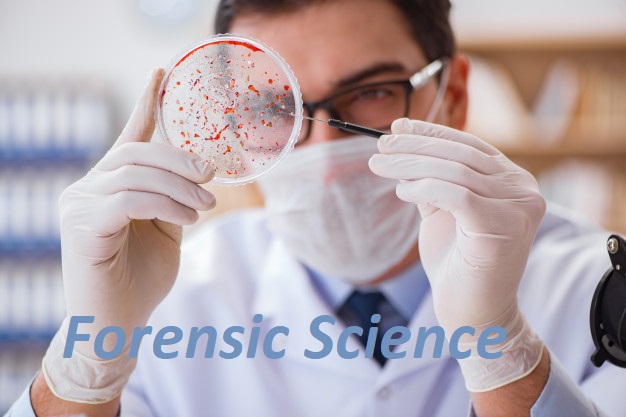

This course has been developed by (Dr A K Gupta Professor and Head,Department of Forensic Science, Sam Higginbottom Institute of Agriculture, Technology & Sciences SHIATS, Allahabad).The Pi of this subject is (Prof.A K Gupta Professor and Ex-Head, Department of Chemistry, Ex-Dean, School of Forensic Science, Sam Higginbottom Institute of Agriculture, Technology & Sciences, Allahabad)and team members/contenr writers are (A.K. Gupta, (.) || Vaibhav Saran, (Department of Forensic Science, Sam Higginbottom Institute of Agriculture, Technology & Sciences SHIATS, Allahabad) || Vaibhav Saran, (Department of Forensic Science, Sam Higginbottom Institute of Agriculture, Technology & Sciences SHIATS, Allahabad) || V. N. Sehgal, (Central forensic Science Lab Head of the Department of ortory ) || Deepika Bhandari, (Head Department of Forensic Science Institute of Forensic Science Mumbai ) || Deepika Bhandari, (Head Department of Forensic Science Institute of Forensic Science Mumbai ) || V. N. Sehgal, (Central forensic Science Lab Head of the Department of ortory ) || Deepika Bhandari, (Head Department of Forensic Science Institute of Forensic Science Mumbai ) || V. N. Sehgal, (Central forensic Science Lab Head of the Department of ortory ) || V. N. Sehgal, (Central forensic Science Lab Head of the Department of ortory ) || V. N. Sehgal, (Central forensic Science Lab Head of the Department of ortory ) || Jaswinder Singh, (Ex-Director CBI, CFSL, HOD & Ex-officio Chemical Examiner to GOI ) || V. N. Sehgal, (Central forensic Science Lab Head of the Department of ortory ) || Prateek Pandya, (Department of Chemistry, University of Rajasthan, Jaipur )).This course is being offered/adopted by this university